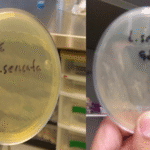
Agares preparados para el transporte estéril de larvas de Lucilia sericata utilizados en larvaterapia.

¿Quiénes somos?
Somos un proyecto académico de la FASBIT-UABJO enfocados en la entomología aplicada en el campo de la investigación, formación y divulgación científica. Asimismo trabajamos en la innovación de bioterapias para el tratamiento de heridas crónicas a través de tratamientos como la larvaterapia y el uso de piel de tilapia.
Nuestras líneas de investigación

Entomología aplicada
La línea de investigación en Entomología aplicada tiene como objetivo aprovechar el conocimiento sobre insectos para desarrollar soluciones en salud, agricultura y medio ambiente. Incluye el estudio de insectos beneficiosos como controladores biológicos, polinizadores y productores de compuestos de interés (por ejemplo, quitina y proteínas).
Mediante la comprensión de su biología, comportamiento y ecología, se diseñan estrategias para el manejo sostenible de plagas, la mejora de la producción agrícola y la conservación de especies útiles.
Foto tomada por: Karyme Lizeth Sánchez Martínez

Larvaterapía
La línea de investigación en Larvaterapia se centra en el estudio y aplicación de larvas estériles de moscas, especialmente de la especie Lucilia sericata, para el tratamiento de heridas crónicas o de difícil cicatrización. Este enfoque terapéutico aprovecha la capacidad natural de las larvas para eliminar tejido necrótico (desbridamiento), promover la regeneración tisular y reducir la carga bacteriana.
El conocimiento generado en esta línea contribuye al desarrollo de tratamientos innovadores y efectivos, ofreciendo una alternativa segura y económica para la medicina humana y veterinaria, y fomentando la investigación en bioterapia avanzada.

Piel de tilapia
La línea de investigación en bioterapia con piel de tilapia está enfocada en el estudio y aplicación de este biomaterial para el tratamiento de quemaduras y heridas complejas. La piel de tilapia posee propiedades únicas, como alto contenido de colágeno y resistencia mecánica, que favorecen la cicatrización y alivian el dolor.
Mediante investigaciones clínicas y experimentales, se evalúa su eficacia, biocompatibilidad y seguridad, además de sus posibles aplicaciones en distintas áreas de la medicina regenerativa.

Ecología de Insectos y Taxonomía
La línea de investigación en ecología de insectos y taxonomía tiene como objetivo explorar y comprender la diversidad de insectos y sus funciones dentro de los ecosistemas. A través de la identificación y clasificación taxonómica, se estudia la riqueza de especies y su distribución, mientras que desde un enfoque ecológico se analizan sus relaciones con el entorno, su estacionalidad y su respuesta a distintos factores ambientales.
Esta línea permite evaluar la salud de los ecosistemas utilizando a los insectos como bioindicadores, así como entender su papel en procesos clave.
Foto tomada por: Karyme Lizeth Sánchez Martínez
Nuestras líneas de investigación
Entomología aplicada
La línea de investigación en Entomología aplicada tiene como objetivo aprovechar el conocimiento sobre insectos para desarrollar soluciones en salud, agricultura y medio ambiente. Incluye el estudio de insectos beneficiosos como controladores biológicos, polinizadores y productores de compuestos de interés (por ejemplo, quitina y proteínas).
Mediante la comprensión de su biología, comportamiento y ecología, se diseñan estrategias para el manejo sostenible de plagas, la mejora de la producción agrícola y la conservación de especies útiles.
Larvaterapía
La línea de investigación en Larvaterapia se centra en el estudio y aplicación de larvas estériles de moscas, especialmente de la especie Lucilia sericata, para el tratamiento de heridas crónicas o de difícil cicatrización. Este enfoque terapéutico aprovecha la capacidad natural de las larvas para eliminar tejido necrótico (desbridamiento), promover la regeneración tisular y reducir la carga bacteriana.
El conocimiento generado en esta línea contribuye al desarrollo de tratamientos innovadores y efectivos, ofreciendo una alternativa segura y económica para la medicina humana y veterinaria, y fomentando la investigación en bioterapia avanzada.
Piel de tilapia
La línea de investigación en bioterapia con piel de tilapia está enfocada en el estudio y aplicación de este biomaterial para el tratamiento de quemaduras y heridas complejas. La piel de tilapia posee propiedades únicas, como alto contenido de colágeno y resistencia mecánica, que favorecen la cicatrización y alivian el dolor.
Mediante investigaciones clínicas y experimentales, se evalúa su eficacia, biocompatibilidad y seguridad, además de sus posibles aplicaciones en distintas áreas de la medicina regenerativa.
Ecología de Insectos y Taxonomía
La línea de investigación en ecología de insectos y taxonomía tiene como objetivo explorar y comprender la diversidad de insectos y sus funciones dentro de los ecosistemas. A través de la identificación y clasificación taxonómica, se estudia la riqueza de especies y su distribución, mientras que desde un enfoque ecológico se analizan sus relaciones con el entorno, su estacionalidad y su respuesta a distintos factores ambientales.
Esta línea permite evaluar la salud de los ecosistemas utilizando a los insectos como bioindicadores, así como entender su papel en procesos clave.
Conoce nuestro trabajo en el laboratorio de entomología aplicada
Contáctanos
- uabjociencias@gmail.com
- 9511797625
- Avenida Universidad S/N, Universidad Uabjo, 68110 Oaxaca de Juárez, Oax.
- Larvaterapia
- Larvaterapia
- Laboratorio entomología